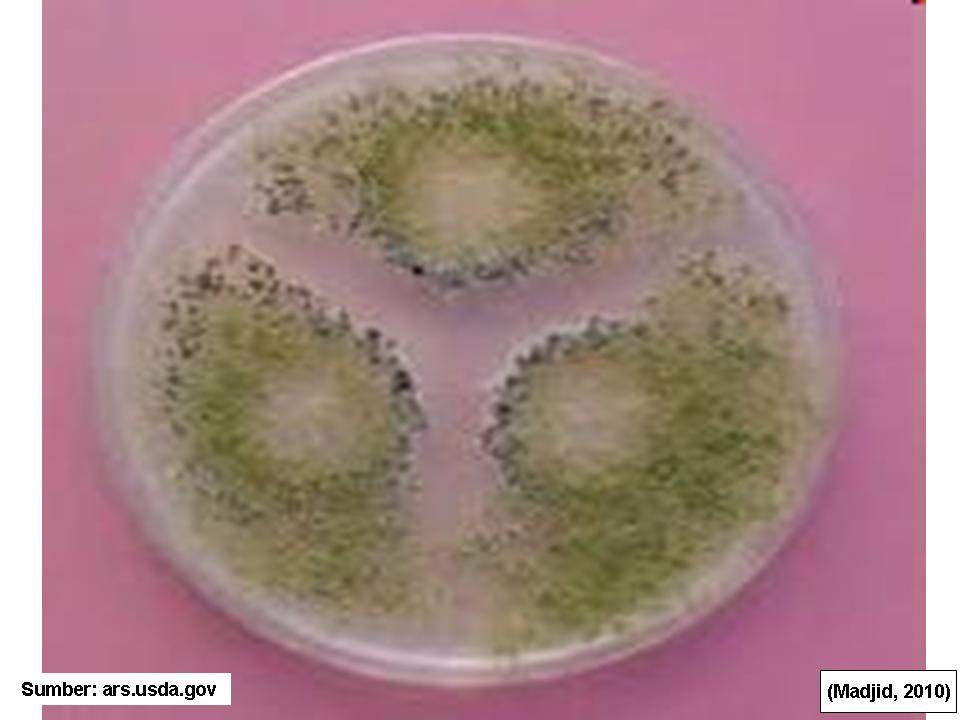
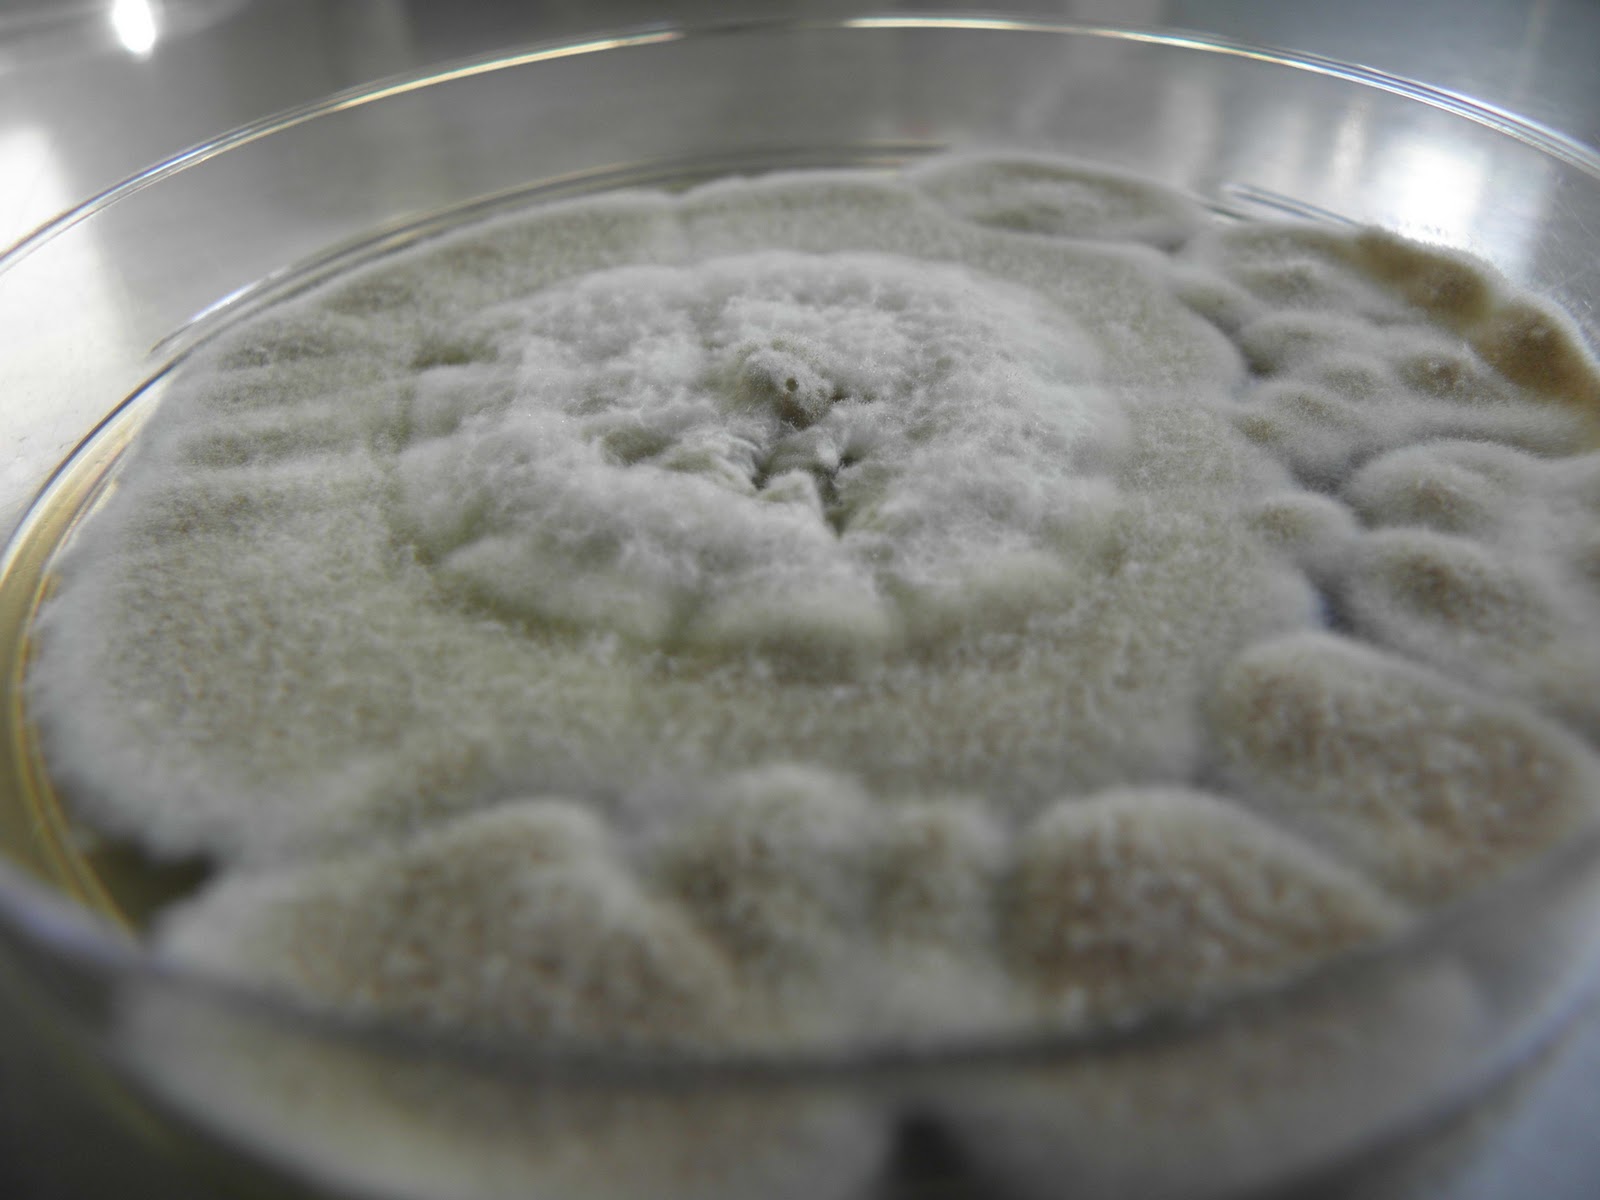

Aspergillus Terreus на Сабуро: фотоматериалы

Раздел: Природная галерея